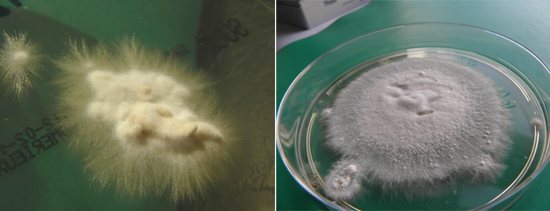
Грибки микроспорум и трихофитон
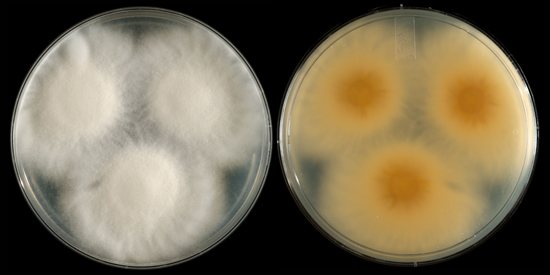
микроспорум пушистый

Фаина Панова
Мы не выбираем, в кого влюбляться. Этот выбор непредсказуем!
calendar_today
6 апреля 2019
visibility
Краткий обзор, какие болезни волос и кожи головы сегодня встречаются очень часто, причины их возникновения, салонные и народные методы лечения, роль трихологии в жизни современного человека. Полезная информация о том, когда стоит бить тревогу и как отличить одно заболевание волос от другого.
Волосы не являются отдельным, самостоятельным органом. Это не более, чем придаток кожи, — данным фактом и объясняется непосредственная зависимость волос от здоровья кожи головы. Она, в свою очередь, отражает, словно в зеркале, все сбои внутренних органов: ослабла иммунная система, неправильно сработал желудок, сдали нервы — всё это отражается на состоянии волос, которые начинают заболевать. Сечься, выпадать, покрываться сальным блеском и перхотью, истончаться, ломаться — много разных напастей выпадает на их долю.
В таких ситуациях болезни волос и кожи головы не всегда можно пролечить самостоятельно, требуется помощь специалистов. Существует отдельная отрасль медицины — трихология («учение о волосах»), — которая изучает строение, болезни, рост, защиту, питание волос и кожи головы.
Именно к трихологам следует обращаться, если возникли проблемы по данному вопросу. Обзор самых частых, актуальных, распространённых сегодня болезней кожи головы поможет определиться, что с волосами не так, почему они начали болеть, как их лечат.
Причины грибкового поражения головы
Микроспория является наиболее распространенной инфекцией волосистой части головы. Причины заболевания:
- В 98% случаев причиной микроспории являются зооантропофильные грибы Microsporum canis (собачий микроспорум) и Microsporum folineum (кошачий микроспорум). Болеют и передают инфекцию человеку кошки (чаще) и собаки (реже). Эти возбудители вызывают поверхностную микроспорию.
- В 2% случаев причиной микроспории являются антропофильные грибы Microsporum audouinii (чаще) и более заразные Microsporum ferrugineum (реже). Эти возбудители вызывают инфильтративно-нагноительную микроспорию.
- Microsporum gypseum и Microsporum nanum обитают в почве. Данный вид микроспории встречается очень редко.
Трихофития волосистой части головы встречается реже микроспории. Ее возбудителями являются:
- Антропофильные грибы Trichophyton tonsurans, реже — Trichophyton violaceum. Вызывают поверхностную трихофитию и также являются причиной хронической трихофитии у взрослых.
- Зооантропофильные грибы Trichophyton mentagraphytes (var. gipseum) и Trichophyton verrucosum (var. faviforme). Заражение происходит от крупных домашних животных и грызунов. Грибы являются причиной развития инфильтративно-нагноительной трихофитии.
Фавус или парша встречается в РФ крайне редко. Его причиной являются антропофильные грибы Trichophyton Schonleinii. Регистрируются случаи заражения от мышей и кошек.
Рис. 3. Колонии грибов Microsporum canis (фото слева) и Trichophyton mentagrophytes (фото справа).
Эпидемиология
- Грибами Microsporum canis заражаются от больных кошек и собак (чаще котят). Болеют, в основном, дети. Заражение у них происходит при непосредственном контакте с животными. К периоду полового созревания отмечается самоизлечение, что связано с нормализацией работы клеточно-гуморального иммунитета.
- Заражение грибами Microsporum gypseum и Microsporum nanum происходит у взрослых, обрабатывающих почву.
- Антропофильными видами грибов, вызывающих микроспорию и трихофитию, заражаются от больных людей и инфицированных предметов быта (наволочки, шапки, косынки, ножницы, расчески и др.).
- Источником грибов Trichophyton mentagraphytes являются домашние животные: крупный рогатый скот, лошади, телята, козы и ослы, а также дикие животные. Источником Trichophyton verrucosum являются мелкие мышевидные грызуны, кролики, суслики и морские свинки. Возможна передача инфекции от больного человека. Заражение от животных происходит при непосредственном контакте, а также через шерсть и чешуйки, которые животные оставляют на почве, сене и кормах. Болеют сельские и городские жители — работники ипподромов, цирков, зоопарков и ветеринарных учреждений. Кроме животных доказана роль в переносе инфекции кузнечиков. Обнаружены трихофитоны в стеблях кукурузы и соломе.
- Фавус распространяется, в основном, среди членов одной семьи. Способствует появлению микоза низкий уровень санитарии и личной гигиены.
Рис. 4. Котята, кошки и собаки — основные источники микроспории.
Рис. 5. Крупный рогатый скот и лошади — основные источники зооантропонозной трихофитии.
Грибковые заболевания кожи лица
Симптомы и особенности. Грибковые заболевания кожи лица довольно часто неправильно диагностируются, поскольку внешние проявления патологии – краснота, отечность, шелушение, зуд подходят под описание нескольких дерматологических проблем, в том числе атопического и себорейного дерматитов, розовых угрей и красной волчанки, которые лечатся гормональными мазями. Применением препаратов, содержащих гормоны, вылечить грибковую инфекцию кожи лица невозможно, а вот изменить клинические проявления и тем самым ухудшить состояние кожных покровов просто.
Симптоматика при грибковых заболеваниях кожи лица зависит от вида грибка, его агрессивности и индивидуальной реакции организма. Обычно на коже появляются розовые (иногда с желтым оттенком) пятна, ограниченные возвышающимся ободком. Пятна, шелушащиеся посередине, обычно разрастаются, при этом волоски, имеющиеся в зоне пятна, не повреждаются. Бывают случаи, когда грибковые заболевания кожи протекают с образованием гнойников, после вскрытия покрывающихся корочками (очень напоминает акне).
Причины. Грибковым заболеванием кожи лица заразиться очень легко, ведь споры грибков буквально витают в воздухе и присутствуют на предметах обихода. Однако для того, чтобы человек реально заболел микозом, у него прежде всего должен быть снижен иммунитет, к чему приводят хронические заболевания, эндокринные нарушения, гипергидроз, гиперкератоз, а так же плохая экология, вредные привычки, длительный прием антибактериальных препаратов, иммуносупрессоров и целый ряд других факторов, негативным образом сказывающихся на состоянии иммунной системы человека. Причиной возникновения грибковой инфекции на лице могут стать уже существующие у пациента очаги заболевания, например, грибки на коже кистей и стоп, а так же использование полотенца, принадлежащего больному человеку.
Виды. Грибковые заболевания кожи лица вызываются грибками рода Т. Rubrum (руброфития) и Т. Mentagrophytes (эпидермофития), реже развитие микоза провоцируется грибками родов M. Canis (зоофильные микроспорумы), М. Audouinii (антропофильные микроспорумы), Т. Concentricum (черепицеооразный лишай).
Лечение. Во-первых, следует провести диагностику, то есть лабораторные исследования соскоба, позволяющие точно сказать, поражена ли кожа грибком. Грибковые заболевания кожи лечатся по двум направлениям: непосредственным воздействием на возбудителя (уничтожение грибка) и проведением мероприятий, направленных на укрепление иммунной системы пациента. Применяют пероральные (таблетки) противомикотические препараты Гризеофульвин, Тербинафин (торговое название Ламизил), Дифлюкан, Кетоконазол (Низорал), Итраконазол (Орунгал) и Флуконазол. Все эти препараты нужно принимать достаточно долго, что может негативно сказаться на состоянии печени, поэтому врачебный контроль при лечении микозов кожи обязателен. Частично избежать побочных эффектов позволяют современные противогрибковые мази: Бифоназол, Клотримазол, Миконазол и Тербинафин. Мазь обычно наносят два раза в день (если врач не прописал иной схемы применения) и продолжают использовать даже после исчезновения симптомов заболевания (во избежание рецидива). Терапия микоза не обходится без приема витаминов и пробиотиков (для нормализации кишечной флоры).
Внимание! Грибковые заболевания кожи лица часто возвращаются, поэтому после проведенного курса лечения следует придерживаться правил: никогда не использовать чужие мочалки, полотенца, щетки и другие предметы гигиены; тщательно дезинфицировать раны на коже, в том числе полученные при бритье; вести здоровый образ жизни; ограничить потребление сахара.
Признаки поражения грибами волосистой части головы
Различают поверхностную и инфильтративно-нагноительную формы микроспории и трихофитии. У части больных трихофития приобретает хроническое течение.
Поверхностная форма микроспории
Спустя 5 — 7 дней после заражения на коже головы появляются 1 — 2 крупных очага (3 — 5 см. в диаметре) поредения волос и множество мелких (0,1 — 0,3 см. в диаметре). Очаги округлые, имеют четкие границы, покрытые серовато-белого цвета (асбестовидными) чешуйками. Воспаление выражено слабо или отсутствует.
Волосы при микроспории обламываются не у корня, как при трихофитии, а на высоте 4 — 8 мм., отчего кажутся подстриженными (вид скошенного луга), легко выдергиваются, окружены, как муфтой, скоплениями спор грибов. Спустя 10 — 12 дней от начала заболевания можно увидеть изумрудного цвета свечение в лучах люминесцентной лампы Вуда.
Рис. 6. На фото грибок кожи головы — микроспория.
Рис. 7. На фото грибок кожи головы — микроспория или стригущий лишай.
Поверхностная форма трихофитии
Спустя 6 — 7 дней после заражения на коже головы появляются единичные очень мелкие (мелкоочаговая форма) или крупные (крупноочаговая форма) очаги. Часть очагов поражения увеличивается в размерах за счет слияния, в результате чего кожа головы оказывается покрытыми множеством шелушащихся плешинок. Крупные очаги имеют неправильную форму и нечеткие очертания. Воспалительный компонент слабо выражен.
Волосы на голове обламываются у корня — на высоте 2 — 3 мм, в результате чего кожа имеет вид черных точек. Пораженные волосы тусклые, теряют эластичность, становятся хрупкими, приобретают серую окраску и утолщаются. У части волос концы изогнуты в виде крючка. Наряду с обломанными волосами отмечается рост здоровых волос. Свечение под лампой Вуда отсутствует.
Без лечения болезнь длится годами и зачастую принимает хроническое течение, что наблюдается только у женщин. У мужчин трихофития самоизлечивается. В ряде случаев наблюдается поражение области роста усов и бороды.
Рис. 8. На фото грибок кожи головы — «черноточечная» трихофития.
Рис. 9. На фото трихофития области роста усов.
Сечение
Многие считают, что секущиеся кончики — это не более, чем косметический дефект, который проходит сам собой и не требует никакого лечения. Это мнение ошибочно, потому что волосы, которые начинают сечься в любом месте своего стержня, — это болезнь, которая знакома трихологам. Проявляется данное заболевание чаще всего на фоне чрезмерной сухости волос.
При этом можно наблюдать самые разные симптомы:
- безжизненный, тусклый вид волос;
- расщепление прядей по всей длине, а не только кончиков;
- сильная спутанность, которая осложняет процесс расчёсывания;
- ослабленность и истончение волос;
- ломкость, а также сопровождающее болезнь выпадение прядей правильнее считать следствием секущихся волос, а не её симптомами.
Как и лечение остальных болезней кожи головы и волос, от посечений нужно избавляться, исключив из своей жизни неблагоприятные факторы, которые могли спровоцировать данное заболевание.
Это могут быть постоянные стрессы, бесконтрольный приём лекарств, плохое питание, злоупотребление феном, некачественное окрашивание, частые химические завивки, мытьё головы хлорированной водой. Если постараться избавиться от этого набора и обеспечить волосам правильный уход, скорее всего, вам никогда не придётся иметь дело с секущимися кончиками.
Особенности поражения волос при трихофитии
Trichophyton ectothrix
Зооантропофильные трихофитоны относятся к группе Trichophyton ectothrix (ecto — снаружи). Они имеют крупные и мелкие споры, которые образуют у основания волос футляры: более широкие — крупноспоровые, более узкие — мелкоспоровые. Наряду со спорами в периферической области волоса встречаются короткие или длинные цепочки спор округлой формы. Trichophyton ectothrix являются причиной развития инфильтративно-нагноительных процессов и гнойного расплавления фолликулов.
Trichophyton endothrix
Антропофильные трихофитоны относятся к группе Trichophyton endothrix (endo — внутри). Споры этих грибов находятся внутри волоса. Они имеют округлую форму, по размерам крупные (5 — 7 мкм), плотно заполняют волос внутри, не выходя за их пределы, располагаются либо в виде цепочек, либо заполняют волос, как мешок с орехами.
Рис. 10. Trichophyton ectothrix: споры возбудителей окутывают волос снаружи, как муфта (фото слева). Trichophyton endothrix: внутренняя часть волоса набита спорами (фото справа).
Алопеция: болезнь или нечто большее?
Алопецией называется не конкретное заболевание, а проявление некоторых патологий в форме облысения или просто повышенного выпадение волос. Алопеция почти никогда не является самостоятельным заболеванием, а лишь симптомом одного или нескольких нарушений организма. Если же она выступает самостоятельным недугом – то, как правило, в виде осложнения после перенесенных кожных заболеваний или неправильного ухода за волосами.
Несмотря на то, что больше никак алопеция не проявляется, к нарушению структуры волос отношения она не имеет. Строго говоря, волосы, как лишенные обменных процессов части тела, не могут болеть сами по себе – в отличие от кожи. Но участки у корней, ближе к волосяным фолликулам, уже «встроены» в кровеносную систему, а потому подвержены повреждениям, которые часто ошибочно и принимают за патологию волос.
Инфильтративно-нагноительная форма грибка кожи головы
Причиной развития инфильтративно-нагноительной трихофитии (чаще) и микроспории (реже) являются зоофильные грибы дерматофиты. При заболевании на кожных покровах головы вначале образуются инфильтрированные, резко гиперемированные крупные очаги. Далее отмечается развитие гнойного процесса. Поверхность покрывается корками, при снятии которых обнаруживается гной, выделяющийся из фолликулов (картина напоминает пчелиные соты). Данное образование называют «фолликулярным абсцессом» или kerion Celci (медовые соты Цельсия). Керион сопровождается недомоганием, головной болью и лихорадкой. Региональные лимфоузлы увеличиваются и становятся болезненными.
Рис. 11. Грибок на голове. Начальная стадия воспаления. Отмечается инфильтрация и покраснение в зоне поражения.
Рис. 12. Инфильтративно-нагноительная фаза заболевания.

Рис. 13. Гнойное воспаление фолликулов в области головы.
Рис. 14. Очаг нагноения на голове — керион, напоминает большой абсцесс.
Рис. 15. На фото инфильтративно-нагноительная форма трихофитии в области роста усов и бороды.
Фолликулит
Фолликулит представляет собой гнойное поражение кожного покрова, которое может поражать не только голову, но и другие участки тела.
Особенности данного заболевания рассмотрены ниже:
- В группе риска находятся люди, живущие в странах с жарким климатом или антисанитарных условиях.
- Очаги поражения находятся возле волосяных фолликулов, происходит формирование пустулы с гноем внутри. После вскрытия остается язвочка небольших размеров, которая в скором времени покрывается коркой, состоящей из смеси крови и гноя. Обычно для полного схождения требуется около недели, после отшелушивания корки на ее месте может остаться рубец.
- Лечение назначается в зависимости от формы и причин появления фолликулита. При бактериальном поражении назначаются антибиотики, при герпетическом недуге обязательно прописывается ацикловир, а при грибковом типе назначаются специальные противогрибковые препараты. В более сложных случаях назначаются сильнодействующие препараты, но начальном этапе бывает достаточно обработки пораженных участков зеленой или фукарцином.
Признаки поражения волосистой части головы при хронической трихофитии
Причиной хронической трихофитии волосистой части головы являются антропофильные грибы Trichophyton tonsurans и Trichophyton violaceum. Заболевание у мальчиков, приобретенное в детстве, самоизлечивается к периоду полового созревания. Трихофития у девочек в ряде случаев приобретает хроническое течение, что связано с нарушением функции эндокринной системы. В 80% случаев у заболевших отмечается гипофункция яичников. Болезнь имеет скудные проявления, протекает длительно. Взрослые становятся источником инфекции для детей.
Поражаются, в основном, затылочная и височная области головы. Очаги небольшие, бледно-розовой окраски, с диффузным или мелкоочаговым шелушением. Обломанные волосы у корней напоминают черные точки (черно-точечная трихофития). Участки поражения зачастую выявляются с трудом.
Рис. 16. Грибок на голове. Хроническая форма трихофитии.
Выпадение волос
Чрезмерное выпадение волос обуславливается разными провоцирующими факторами. Это могут быть как внутренние заболевания, так и непосредственное повреждение фолликулов.
У людей в возрасте поредение шевелюры связано с возрастными изменениями.
ПОПУЛЯРНОЕ У ЧИТАТЕЛЕЙ: Велпанат — новый шаг в сторону лечения гепатита
Алопеция
Термином алопеция обозначается прогрессирующая потеря волос, приводящая к частичному или полному облысению. Алопецию подразделяют на диффузную, очаговую и андрогенную.
.
Проблема может коснуться и мужчин, и женщин, с данным косметическим дефектом больше всего людей после 50 лет.
Облысение не только ухудшает внешний вид, но и доставляет немало психоэмоциональных переживаний.
Эффективное лечение алопеции довольно трудно подобрать без выяснения основной причины чрезмерного выпадения локонов. В некоторых случаях врач-трихолог может прописать пожизненное использование ряда наружных средств, позволяющих вернуть густоту волосяного покрова.
Фавус — редкая форма микоза головы
Фавус (парша) в РФ встречается крайне редко. Его причиной являются грибы Trichophyton schоnleinii. Болезнь поражает ослабленных людей (чаще детей), страдающих тяжелыми истощающими заболеваниями. Способствует его развитию низкий уровень санитарии. Возбудители передаются при контакте с больным человеком или его вещами. Микоз головы протекает тяжело и длительно. Заболевание характеризуется появлением на коже головы зловонных корок (скутул, щитков) с последующим развитием на кожных покровах рубцово- атрофических изменений и алопеции. В период полового созревания у детей заболевание самопроизвольно не излечивается.
При классической картине микоза на коже головы появляются скутулы — грязно-желтой окраски, сухие, блюдцеобразной формы корки, которые представляют собой колонии грибов, плотно окружающих волос. Вначале скутулы единичные, далее множественные, в запущенных случаях они покрывают всю голову, от которой исходит неприятный амбарный (мышиный) запах.
При сквамозной форме заболевания поражение кожи головы напоминает себорейную экзему, при импетигинозной форме на участках поражения появляются пустулы.
Рис. 17. Скутулы при фавусе.
Рис. 18. На фото скутулярная (слева) и импетигинозная (справа) формы фавуса.
Рис. 19. Тяжелая форма фавуса. Скутулы покрывают всю голову.

Другие заболевания волос
Гипертрихоз
Термином гипертрихоз в медицине обозначается усиленный рост волос на разных участках тела – спине, бедрах, предплечьях, животе, ягодицах, груди.
.
Такое оволосение не обуславливается действием андрогенов. Заболевание встречается у женщин и мужчин, тогда как другая патология со сходными проявлениями – гирсутизм может быть только у женщин.
Основные причины гипертрихоза:
- Врожденные мутации генов, возникающие вследствие воздействия неблагоприятных факторов на развивающийся плод;
- Длительное использование некоторых медикаментов;
- Последствия ЧМТ.
Лечение подбирается исходя из данных гормонального и дерматологического обследования человека.
Если эффективных лекарств от гипертрихоза не удается подобрать, то пациенту предлагается удаление ненужных волос методом электроэпиляции.
ВАЖНО ЗНАТЬ: Что такое трихотилломания и как лечить заболевание.
Жирные волосы
Чрезмерная сальность локонов возникает по причине повышенной активности сальных желез, находящихся в коже головы.
Жирные локоны практически всегда выглядят неопрятными, маслянистыми, они легко и быстро загрязняются, появляются склеенные прядки.
При жирном типе волос проблему решить не помогает даже частое мытье кожи головы, а укладка в красивую прическу практически неосуществима.
При жирном типе волос требуется профессиональный подход к устранению дефекта. Необходима не только консультация трихолога, но и обследование у гастроэнтеролога, дерматолога, эндокринолога.
Комплексное лечение заключается в применении специальных лосьонов, бальзамов и шампуней.
Пациенту назначают физиопроцедуры – дарсонвализацию, мезотерапию, рекомендуется курсовое использование фитосборов, лечебных сывороток, масок.
Ранняя седина
О ранней седине свидетельствует появление большого количества седых волос до 25 лет и обесцвечивание большей части локонов еще до 40 лет.
Проблема возникает по причине нарушения функционирования меланоцитов, что в свою очередь вызывается разными внутренними изменениями в организме.
Чтобы приостановить раннее поседения требуется вовремя проконсультироваться с трихологом, сдать анализы на выяснение показателей микроэлементов и витаминов в крови, определить соотношение гормонов щитовидной железы.
Процесс обесцвечивания локонов замедляется после курса массажа головы, путем мезотерапии, помогают в этом и маски, и различные аппаратные процедуры.
Тонкие волосы
Волосы, имеющие диаметр меньше 50 мк, считаются тонкими. Такие локоны отличаются чрезмерной мягкостью, они быстро спутываются, плохо расчесываются и им не хватает объема.
Толщина и густота волос увеличивается при помощи использования различных ампульных препаратов, сывороток, профессиональных масок, неплохие результаты дает мезотерапия и массаж кожного покрова головы.
Но чтобы добиться заметного результата требуется помощь трихолога.
Проблему могут помощь решить и парикмахеры. Кератиновое протезирование локонов, их ламинирование и наращивание делают локоны прочнее, толще и привлекательнее.
Сухие ломкие волосы
Сухость волос и их повышенная ломкость чаще всего возникают по причине хронических болезней органов пищеварения, эндокринной и мочевыделительной систем, паразитарных заболеваний.
Потеря влаги внутри стержня может быть обусловлена и неправильным окрашиванием, и термическим воздействием. В редких случаях это аномалия возникает при узелковой трихоклазии.
Вернуть нормальное состояние волосам возможно только при устранении основной причины изменений. Дополнительно трихолог назначает использование средств, усиливающих увлажнение и прочность локонов. Патологические изменения структуры волос и заболевания кожи головы имеют определенную причину их появления.
Полное обследование позволит понять, чем вызвано ухудшение состояния локонов, а это в свою очередь самое главное в выборе препаратов, помогающих решить косметическую и дерматологическую проблему.
Диагностика микоза волосистой части головы
Диагностика грибка кожи головы основывается на сборе эпидемиологического анамнеза, клинической картине заболевания и лабораторной диагностики.
Микроскопия
При данном виде исследования обнаруживаются споры и мицелий грибов, но провести дифференцировку микроскопии от трихофитии невозможно. Идентифицируются микроорганизмы с помощью культурального метода с последующей микроскопией. Материалом для исследования служат чешуйки и волосы больного, взятые из периферической зоны очага поражения.
Рис. 20. Микроскопическая картина Microsporum canis (микроспорума пушистого). Хорошо виден мицелий (фото слева) и многочисленные экзоспоры (фото справа).
Культуральное исследование
Самым достоверным признаком грибка кожи головы является обнаружение роста возбудителей на питательных средах. Микроскопия полученного материала позволяет идентифицировать вид грибов.
Рис. 21. Вид колоний Microsporum canis (микроспорума пушистого). Выявляется у больных микроспорией в 98% случаев.
Установление тканевой формы трихофитонов
При микроскопии пораженных волос устанавливается тканевая форма трихофитонов:
- Зооантропофильные трихофитоны относятся к группе Trichophyton ectothrix (ecto — снаружи). Споры этих грибов находятся снаружи волоса. Трихофитоны этого вида являются причиной развития инфильтративно-нагноительных процессов на коже головы.
- Антропофильные трихофитоны относятся к группе Trichophyton endothrix (endo — внутри). Споры этих грибов находятся внутри волоса.
Рис. 22. Поражение волоса Trichophyton ectothrix.
Рис. 23. Поражение волоса Trichophyton endothrix.
Диагностика грибка кожи головы с помощью люминесцентной лампы Вуда
Свечение изумрудной окраски в лучах люминесцентной лампы (лампы Вуда) характерно только для микроспории.
Рис. 24. Флюоресценция(свечение) волос в лучах люминисцентной лампы при микроспории.
Лечение грибковых инфекций медикаментами
Медикаментозное лечение грибка кожи головы включает в себя использование противомикозных мазей, прием таблеток, применений лечебных шампуней.
Препараты наружного действия (крем, мазь, гель, аэрозоль) быстро снимают неприятные симптомы и убивают грибок. Но иногда споры грибка проникают глубоко в эпидермальные слои и мягкие ткани, и одних только наружных средств может быть недостаточно.
Лекарство для приема внутрь (таблетка, капсула, суспензия) полностью уничтожает инфекцию. Сегодня разработаны такие медикаменты, где в упаковке всего 1 таблетка, и этой дозы достаточно, чтобы уничтожить грибок в организме.
Противогрибковые шампуни являются хорошей профилактикой болезни и помогают восстановить волосы.
Медикаменты, зарекомендовавшие себя наилучшим образом:
- Мази: Клотримазол, Фундизол, Экзодерил, Тербинафин, Амиклон, Акридерм.
- Таблетки: Нистатин, Леворин, Натамицин, Флуконазол, Ламизил, Тербизил, Кетоконазол, Микосист.
- Шампуни: Микозорал, Кето Плюс, Низорал, Себозол, Дермазол, Циновит.
Если к лишаю присоединилась вторичная бактериальная инфекция, назначают также мазь с антибиотиком (Синтомицин, Мирамистин, Левомеколь).
Все перечисленные медикаменты имеют противопоказания и побочные действия. Любые лекарственные препараты для лечения грибка головы должен назначать врач. Лечение микозов, как правило, происходит в домашних условиях. В редких случаях при обширном поражении и при вторичных гнойных инфекциях пациента кладут в стационар.
Лечение грибка кожи головы
При поражении волосистой части головы применяется комплексное лечение, включающее системные антимиотики, местное применение противогрибковых препаратов и антисептиков, удаление волос в зоне поражения.
Волосы в очаге сбриваются. При черноточечной (хронической) трихофитии производится отслойка рогового слоя эпидермиса по Ариевичу.
Из системных антимиотиков применяются Гризеофульвин, препараты, содержащие тербинафин и кетоконазол, Флуконазол и Интраконазол.
Противогрибковые мази и гели для местного применения представлены антимиотиками разных групп. Широко применяются Ламизил, Экзодерил, Микоспор, Клотримазол, Бифоназол, Оксиконазол и др.
При местном лечении обязательно используются антисептики: 2 — 5% настойка йода, раствор фурациллина, калия перманганата и риванола.
Хорошим отшелушивающим эффектом обладают препараты, содержащие серу, деготь и ихтиол. Кератолитическими свойствами обладает салициловая кислота. Показаны апликации серно-салициловой мази и смазывание очагов поражения 2% настойкой йода.
При явлениях выраженного воспаления применяются комбинированные препараты, содержащие кортистероидные гормоны.
При фавусе применяется гризеофульвин внутрь. Можно применять препараты, содержащие интраконазол или тербинафин. Удаление скутул производится путем применения салициловой мази.
Подробно о лечении микроспории, трихофитии и фавуса читай в статьях «Микроспория», «Трихофития» и «Фавус».
При малейшем подозрении на заболевание кожи головы обращайтесь к врачу дерматологу. Только в условиях специализированного лечебного учреждения вам поставят правильный диагноз и назначат адекватное лечение. Неправильная терапия усугубляет течение грибкового заболевания и повышает риск заражения контактных лиц.
Рис. 25. Результат правильного лечения грибка кожи головы
Себорея
Себорея является воспалительным заболеванием, которое хотя бы иногда проявляется у каждого чётвертого жителя Земли. Оно начинается, когда в работе сальных желез возникают сбои. В зависимости от характера этих сбоев выделяют два основных подвида себореи:
- Если железы начинают вырабатывать слишком много кожного сала, то тогда у человека проявляется жирная себорея.
- Если железы начинают вырабатывать слишком мало кожного сала, то тогда у человека проявляется сухая себорея.
Определить, что заболевание начало развиваться, можно по:
- сильной перхоти;
- шелушению кожи головы;
- зуду;
- излишней сухости или быстрому засаливанию;
- выпадению волос.
Также утолщается роговой слой кожи. Чаще всего провоцируют развитие заболевания гормональные изменения – потому так часто оно проявляется в подростковом периоде. Причиной могут быть также другие заболевания и патологии, протекающие в организме, включая болезнь Паркинсона, энцефалит и другие, а также наличие на коже грибковых микроорганизмов.
При провоцировании себореи сторонним заболеванием, необходимо начать терапию именно с устранения этой проблемы, а потом уже переходить к нормализации состояния кожи головы.
Избавление от недуга аптечными препаратами
В аптеках можно найти шампуни на основе цинка, они отлично справляются с проявлениями себореи. Также часто приобретают шампуни, в составе которых содержатся деготь и кетоконазол. Достаточно мыть ими голову два раза в неделю, чтобы через некоторое время проявился заметный эффект. Когда себорея отступит, рекомендуется продолжать использовать их хотя бы два раза в месяц в чисто профилактических целях.
Дегтярный шампунь от себореи
Дополнительно к этим средствам рекомендуется использовать противогрибковые шампуни, назначаемых доктором, если себорея была спровоцирована проявлениями грибка. Иногда доктор может дополнительно назначить местные гормональные препараты, а если проблема находится в достаточно тяжёлой стадии, то и принимаемые внутрь.
Наиболее популярным средством в терапии себореи в последнее время стал считаться кетоконазол, который принимают по 200 мг в сутки. В сочетании с этим препаратом часто употребляют успокаивающие лекарства и таблетки для нормализации работы ЖКТ.
Домашнее лечение
Можно вылечить себорею при помощи простых рецептов домашних масок, которые готовятся из натуральных средств. Например, можно приготовить отвар из равных частей ивы, высушенной крапивы и лопуха. Смесь надо залить горячей водой и полчаса доготовить на водяной бане. После этого нужно мыть голову такой смесью хотя бы пару раз в неделю.
Также можно сделать маску для кожи головы, если смешать репейное масло с несколькими каплями эфирного масла чайного дерева. Маска наносится на голову, после чего через некоторое время волосы моются.